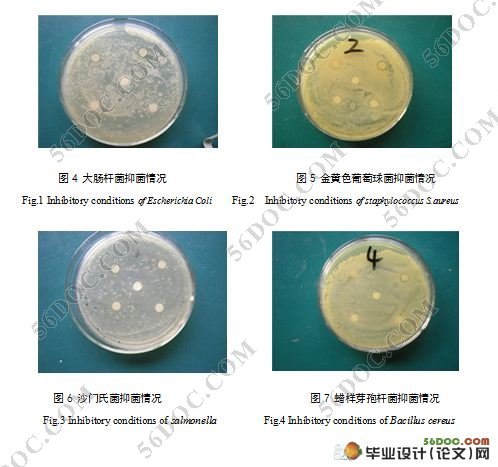

刺葡萄酒中抗菌活性成分分析及其抗菌谱研究
来源:56doc.com 资料编号:5D5842 资料等级:★★★★★ %E8%B5%84%E6%96%99%E7%BC%96%E5%8F%B7%EF%BC%9A5D5842
资料以网页介绍的为准,下载后不会有水印.资料仅供学习参考之用. 密 保 惠 帮助
资料介绍
刺葡萄酒中抗菌活性成分分析及其抗菌谱研究(10000字)
摘 要:本文探讨的是刺葡萄酒中活性成分以及测定其抑菌活性效果,在实验中提取葡萄酒中活性成分,然后采用试管两倍稀释法对金黄色葡萄球菌、沙门氏菌、大肠杆菌、蜡样芽孢杆菌进行抑菌实验。刺葡萄酒中活性成分对金黄色葡萄球菌、沙门氏菌、大肠杆菌、蜡样芽孢杆菌均有不同程度的抑菌作用且得金黄色葡萄球菌、蜡样芽孢杆菌、大肠杆菌的最小抑菌浓度均是62.5μg•ml-1,而沙门氏菌的最小抑菌浓度为31.20μg•ml-1。
关键词:黄酮;白藜芦醇;抑菌作用
The Study on Composition and Antibacterial Activity of Antimicrobial Spectrum of Spine Grape Wine
Abstract: This paper discusses the active ingredient in wine and stabbed the inhibitory activity measured results, extracting the active ingredient in wine, then double dilution method in vitro against Staphylococcus aureus Salmonella, E. coli, Bacillus cereus. Active components in wine Staphylococcus aureus, Salmonella, E. coli, Bacillus cereus, have different levels of inhibition. Staphylococcus aureus, Bacillus cereus, Escherichia coli minimum inhibitory concentration are 62.5μg • ml-1, while the minimum inhibitory concentration of Salmonella 31.20μg • ml-1.
Key words: Flavonoid; ReserVatrol;Antibacterial activity
|